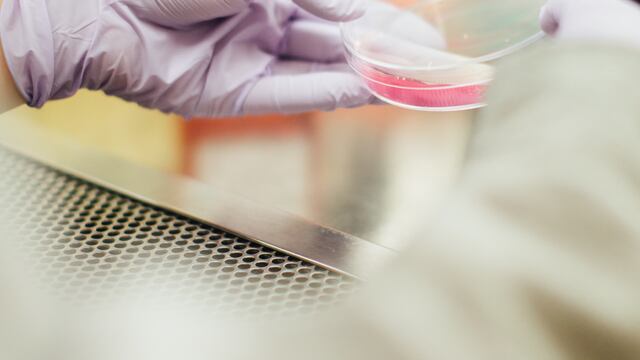
Logran convertir células de cáncer en grasa

La cura para el cáncer podría ser ya una realidad, gracias a científicos de la empresa australiana de biotecnología Imugene, quienes afirman haber creado un virus similar al de la viruela bovina (cowpox virus), que es capaz de matar cualquier tipo de células malignas.
El científico estadounidense Yuman Fong, líder de la investigación, explicó que el tratamiento denominado CF33, se logró al mezclar la viruela bovina con otros virus.
Las pruebas en cajas de Petri demostraron que el coctel podía matar todo tipo de cáncer y reducir los tumores en ratones, indicó.

Con base en estos resultados, Imugene ya planea ensayos clínicos en pacientes con cáncer de mama y otros tipos de la enfermedad, para el año próximo en Australia y otros países.
“Pacientes con cáncer de mama triple negativo, melanoma, cáncer de pulmón, vejiga, cáncer gástrico e intestinal se evaluarían en el 'estudio de canasta'”.
Yuman Fong, líder de la investigación.
Fong explicó que los pacientes con cáncer recibirían una inyección de CF33 directamente en sus tumores.
De esta forma, se espera que el nuevo virus infecte las células de cáncer y las haga explotar. Esto alertaría al sistema inmune sobre otras células cancerosas en el cuerpo e iniciaría su exterminio.

A nivel mundial, los diagnósticos de cáncer han ido en aumento, convirtiendo a la enfermedad en una de las principales causas de muerte entre los seres humanos.
En 2012 se registraron 14 millones de casos nuevos y 8.2 millones de personas fallecidas, según el Informe Mundial sobre Cáncer 2014 de la Organización Mundial de la Salud (OMS).



Según cálculos del documento, en 2018 los enfermos de cáncer habrían ascendido a 18 millones de casos nuevos y 9.6 millones muertes.
Fong reconoce que el éxito obtenido con los ratones no garantiza que el virus pueda tratar a los humanos, pero se mantiene optimista debido a que otros virus específicos han comprobado su efectividad para combatir el cáncer en ambas especies.
Por ejemplo, indicó, el virus que causa el resfriado común fue convertido en un tratamiento para el cáncer de cerebro en Estados Unidos. La enfermedad desapareció en algunos pacientes durante varios años, mientras que en otros se redujeron considerablemente los tumores.

Asimismo, se descubrió que una forma del virus del herpes labial llamada Imlygic o T-Vec era capaz de tratar el melanoma, ya que ayudaba al sistema inmunitario del cuerpo a reconocer y destruir tumores y células de melanoma en el cuerpo.
"Hubo evidencia de que los virus podían matar el cáncer desde principios de 1900, cuando las personas vacunadas contra la rabia vieron su cáncer desaparecer, entraron en remisión”
Yuman Fong, líder de la investigación.
El problema, dijo, fue que surgieron preocupaciones de que los virus llegaran a ser demasiado tóxicos para los humanos y se volvieran fatales.
Al respecto, Fong recordó que la viruela vacuna demostró proteger con éxito a las personas contra la viruela hace 200 años y se demostró que es inofensiva para los humanos.
Con información de Daily Mail.